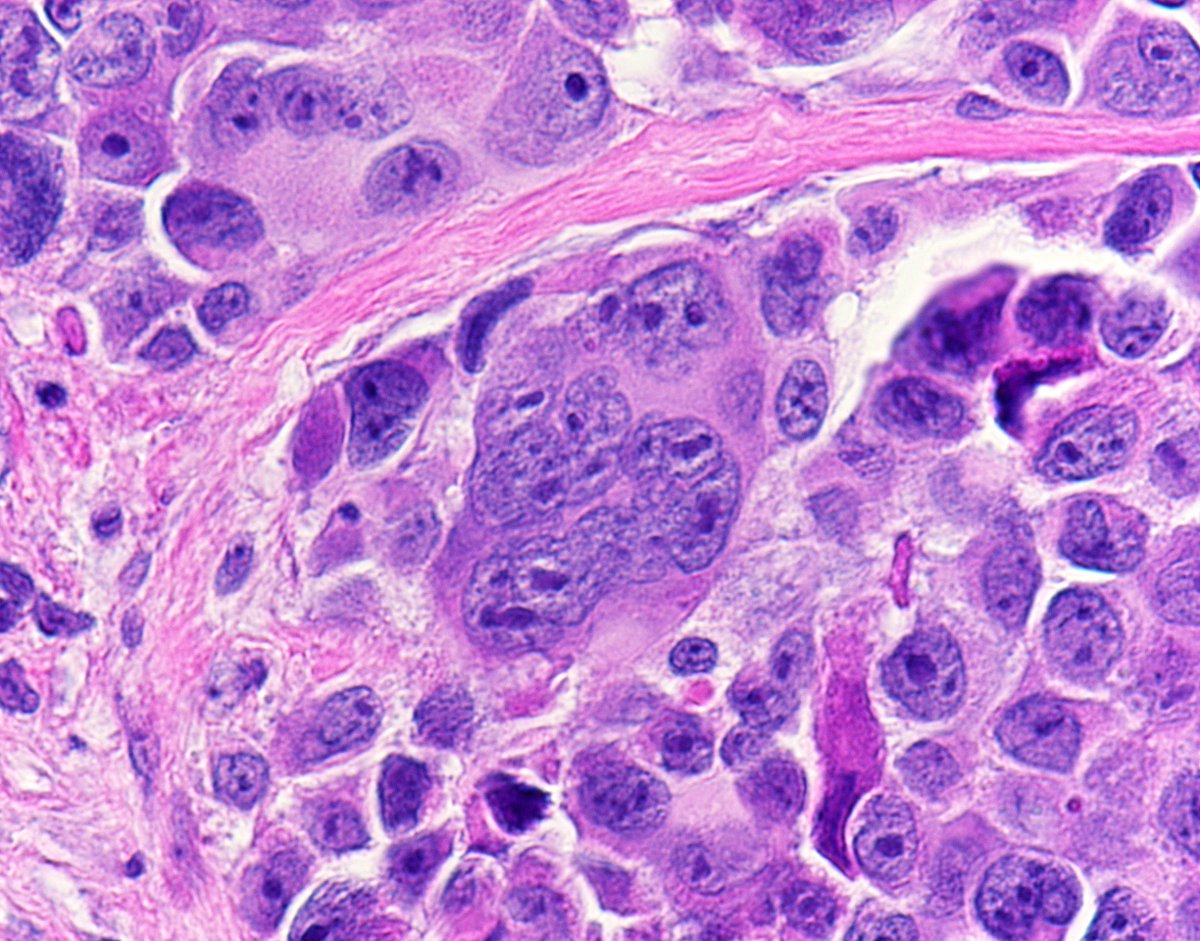

Dermatologists in France
When most people hear about a dermatologist, probably the first thing that comes to their mind is skin problems and strange infectious diseases. Reality is that dermatologists are charged with the task of not only dealing with skin problems but also with problems related to the hair and nails as well.
As a specialist doctor—one that is very concerned with cosmetic and beauty—, a dermatologist is also a surgeon, but in a narrower sense: only concerned with his field of expertise.
Now, when it comes to France, its people are known for being baguette and wine lovers (also with a beret on their heads), but the stereotype that may stand out the most, is that of their exquisiteness, sometimes with elegance and grace as well. This is why the dermatologist and skincare industry could be so interesting to inspect close up in the land of romance and croissants.
You see, thanks to the French colonial empire (1534-1980) with its overseas territories and colonies—especially in Africa—, nowadays, France is one of the most diverse countries when it comes to demography and race: thousands of people originally from Africa have already migrated to France and this has created an interesting mixture of cultures.
Now, why do I mention this little piece of French history?
Simple: as of today, the skincare industry is still ignoring people of color around the world. And this is a general perception according to an article from The Guardian, not only from the people of color (Asians, blacks, etc.) but also from dermatologists as well, as the UK’s leading ethnic dermatologist Dr. Ophelia Dadzie mentions in that article. This is common not only in the UK but also in Europe as well.
Nonetheless, this diversity, only found in the European continent within France, may help to shift the current sentiment and perception of this industry and start to transform it with new market segments, beneficial to everyone, and French dermatologists can be a part of this as well.
For the most part, people of color with melanin-rich skins have had to turn to niche products, designed specifically for them, which have advantaged and different components when compared to the mainstream skincare products designed for white people. There exists a need, therefore, to reduce the number of toxins and dangerous components included in most of the existing skincare products to further include more people.
French dermatologists can be the bridge between supply and demand, and the executioners of this needed transformation. A hidden potential lies among the French culture which can give rise to a new line of products to equilibrate the market and satisfy the needs of those millions of people of color in France. Hopefully, this may be the first example and not the last in the industry. The good thing is that more variables are positively affecting this potential change within the industry.
In fact, one big advantage that France has over most of the countries in the world is its universal health care system. First proposed by Prime Minister Lionel Jospin (a member of France’s Socialist Party), this became a reality in 1998 when the health care system became universal: now it is a right of every resident of France. And, as the World Health Organization underscored in one of its assessments of the World’s Health Systems, “France provides the best overall health care followed among major countries by Italy, Spain, Oman, Austria, and Japan.”
This is quite impressive, and very beneficial too for dermatologists in France and for people demanding their services. Although they’re not making as much as American doctors in general, it must be stressed that French doctors do not have to pay tuition for medical school, and they get paid as well during their training in hospital internships. Also, thanks to this innovative system which requires less than 6% of a common French’s income in most of the cases, people still have to pay when going to the doctor or the dermatologist; the difference and the innovation appears at the moment of paying: on average, people get reimbursed 75% to 80% of their expenses, except the cases where cancer or diabetes is present (then they would get a 100% reimbursement)
In this way, all the different sub-branches of dermatology—i.e., immunodermatology, dermatopathology, cosmetic dermatology, etc.—, can properly develop and foster in an environment where not only the government allocates and distributes the amount of money for the different funds that compose this system, but also the private sector participates and actively engages. This public-private partnership ensures the existence of a limit on the State’s bureaucracy and allows insurance companies (some of them nonprofit) and private investors to negotiate with the government and provide both an affordable and high-quality service.
In this day and age, especially in countries like South Korea, people are demanding more cosmetic dermatology services than ever before. Maybe this is an obsession with the idea of having the perfect skin, similar to what occurs with some people in China, where they definitely forbid their skin to come in contact with the sun by using special swimsuits that cover almost their entire bodies. This phenomenon or obsession is starting to take place in other parts of the world, to the point where it is already reaching France.
In fact, a recently published research report titled “Worldwide Dermatology Lasers Market Research” forecasts a sustained growth for the Global Dermatology Lasers Market till the year 2024, impacting all market segments, including the European one, where France is included. This is more proof of this phenomenon coming from Asia in recent years.
Now, some may see this phenomenon as something negative, others, such as most of dermatologists, as something to celebrate; because, indeed, these skincare doctors sometimes recommend measures and routines which may seem very strict to most people. Some of these measures include drinking at least 2 liters of water a day, applying sunscreen every day, even when it is cloudy and even when you’re inside your home or apartment where the impact of UV rays is minimum.
The reason for all of this? Protection.
Truth is that most of the skin diseases and conditions are worsened when exposed to the sun due to the dangerous UV rays, which can also make you older prematurely. For example, acne scars, dark marks, and even blackheads can produce a pretty terrible outcome if the skin surrounding them is “kissed” by the sun. In this sense, hyperpigmentation can be a big issue since acne marks can last for months if sunscreen is not applied when the sun is burning heavily.
And this is true even for people of color! For example, black people can still get marks on their facial skin, and winter is not so amusing for them either. That’s why there’s a need for a culture change in the skin care industry, which can effectively help their skins.
However, the wide access people have to healthcare in France may help dermatologists to provide practical advice instead of more medical procedures, surgeries or prescriptions with expensive skincare products for specific niches.
Indeed, routines and habits are a big deal in dermatology. Almost two-thirds of our body is composed out of water, thus making the consumption of two or more liters of water a big necessity for all of us, including people with melanin-rich skins. It has been shown in the extensive literature on this matter that drinking more water helps to clean and maintain a healthy and young skin, further facilitates blood circulation, strengthens bones, muscle tissues, and helps the lungs, the kidney and liver to function properly.
Another great advantage that France has alongside most European countries is the types of food offered across the country. Thanks to regulations proposed by the European Union, it turns out that the type of food you find in France may be healthier than the one you may find outside of Europe. These extensive regulations allow citizens to receive food with better, natural ingredients and restrict producers of including addictive and sometimes dangerous components into the production process, thus incentivizing them to find organic alternative options.
Of course, culture plays a big role here. When you look at Asian cultures, especially Japan and South Korea, you would find that their gastronomy is heavily packed with all types of fish, seafood, and omega-3-rich foods as well. Omega-3 is well-known for being an effective agent against inflammatory diseases, especially acne. When combined with Vitamin A, B and Zinc-rich foods (such as eggs, some vegetables, etc.), this can be a very effective cure against acne.
Another very important thing with which dermatologists are concerned, is skin cancer, especially melanoma, which is the worst-case scenario. Melanoma may initially appear under people’s nails (therefore the importance of the dermatology branch of tackling skin, hair and also nails), that’s why it is of the utmost importance to carry out frequent assessments with dermatologists.
In a country like France, although it is not in the top 10, it is indeed within the top 20 countries that are the most susceptible to skin cancer, as shown by the Skin Cancer-Index 2018. They mention with respect to skin cancer that: “it is the most commonly diagnosed cancer worldwide. However, if detected early, it can be one of the easiest to cure.”
Being in the top 20 most susceptible countries to skin cancer isn’t that bad either. In fact, most of the European countries are included above France on that list, with New Zealand, Australia, and Switzerland at the top positions three positions, respectively. Thus, it may not be a matter of lack of resources, a lack of a free market to buy the necessary skin care products or to apply the right treatments. It may just be a matter of culture.
This is when France enters into the stage once again. Having the best universal health care system of the entire world, this can be used to incentivize people, especially those of color, to go to the doctor and receive the appropriate routines to prevent this terrible diseases and tumors. A simple thing such as applying sunscreen can be extremely beneficial to counteract the sun’s rays and the environment’s pollution in some areas.
It is interesting and curious to notice that, at the very bottom of this Skin Cancer-Index, one can find countries from the MENA (Middle East and North Africa) such as Bangladesh, Iraq, Egypt, Saudi Arabia, etc., which may just be an indication that the use of the hijab, in the case of women, and lots of clothes in general, are effectively protecting these people against the dangers of skin cancer.
Now, this study shows even another index, called the Socioeconomic Treatment Index, which “cross-references national health spending and individual income against mortality rates to better understand the efforts undertaken worldwide to combat the disease”, which puts France at a modest 14th position, very close to its relative position in the Skin-Cancer Index. In this sense, other European countries are doing better overall, with Sweden, Switzerland, and Italy in the three top positions, respectively.
This last result could be explained by the amount of government spending allocated to the national health care system in France. As explained by the World Health Organization, in 2014, France spent approximately 11.5% of its GDP (Gross Domestic Product, the total sum of all final goods and services produced within France) on health care. This figure is bigger than the one found in other European countries, although it is less than the one employed by the United States (albeit, it should be noted that the US does not have a universal health care system yet, but just an approximation with the 2010 Affordable Care Act, or just Obamacare).
In summary, France has an enormous potential to make a better use of its national health care system with regards to dermatology, benefiting people of every kind across the country and, hopefully, setting an example as well for the rest of the countries about a true process of inclusion, globalization and diversification to new and different markets that can be attractive to suppliers and the skincare industry if new accords and negotiations are made with the central government, which controls most of the health care system.

Congratulations @freedomanytime! You have completed the following achievement on the Steem blockchain and have been rewarded with new badge(s) :
You can view your badges on your Steem Board and compare to others on the Steem Ranking
If you no longer want to receive notifications, reply to this comment with the word
STOPTo support your work, I also upvoted your post!
Do not miss the last post from @steemitboard:
Vote for @Steemitboard as a witness to get one more award and increased upvotes!